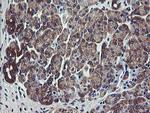
VBP1 Antibody in Immunohistochemistry (Paraffin) (IHC (P))

Search
OriGene
VBP1 Monoclonal Antibody (OTI2F2), TrueMAB™
{{$productOrderCtrl.translations['antibody.pdp.commerceCard.promotion.promotions']}}
{{$productOrderCtrl.translations['antibody.pdp.commerceCard.promotion.viewpromo']}}
{{$productOrderCtrl.translations['antibody.pdp.commerceCard.promotion.promocode']}}: {{promo.promoCode}} {{promo.promoTitle}} {{promo.promoDescription}}. {{$productOrderCtrl.translations['antibody.pdp.commerceCard.promotion.learnmore']}}
产品信息
TA504915
种属反应
宿主/亚型
分类
类型
克隆号
抗原
偶联物
形式
浓度
纯化类型
保存液
内含物
保存条件
运输条件
靶标信息
The protein encoded by VBP1 interacts with the Von Hippel-Lindau protein to form an intracellular complex. The encoded protein functions as a chaperone protein, and may play a role in the transport of the Von Hippel-Lindau protein from the perinuclear granules to the nucleus or cytoplasm. Alternative splicing and the use of alternate transcription start sites results in multiple transcript variants encoding different protein isoforms.
仅用于科研。不用于诊断过程。未经明确授权不得转售。
篇参考文献 (0)
生物信息学
蛋白别名: HIBBJ46; prefoldin 3; Prefoldin subunit 3; RP13-228J13.4; VBP-1; VHL binding protein-1; von Hippel-Lindau binding protein 1; von Hippel-Lindau-binding protein 1
基因别名: HIBBJ46; PFD3; PFDN3; VBP-1; VBP1
UniProt ID: (Human) P61758
Entrez Gene ID: (Human) 7411